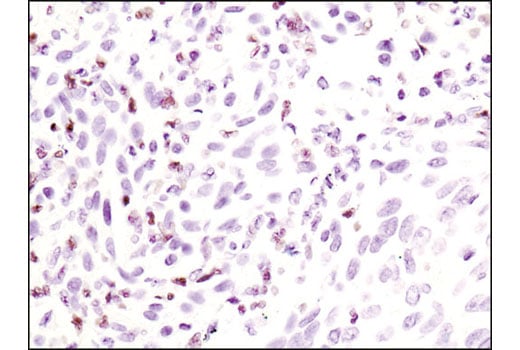

マイストア
変更
お店で受け取る
(送料無料)
配送する
納期目安:
2025.10.12 11:47頃のお届け予定です。
決済方法が、クレジット、代金引換の場合に限ります。その他の決済方法の場合はこちらをご確認ください。
※土・日・祝日の注文の場合や在庫状況によって、商品のお届けにお時間をいただく場合がございます。
ma5ページ Mitsubishi Montero Vehicle Speed Sensor - Reliable Performanceの詳細情報
Mitsubishi Montero Vehicle Speed Sensor - Reliable Performance。Phospho-Stat5 (Tyr694) (C71E5) Rabbit mAb (BSA and Azide。Mitsubishi Montero Vehicle Speed Sensor - Reliable Performance。ma5ページです。ご本人様以外ご購入されませんようにお願いいたします。耳を澄ませば、あちらこちらからシマちゃんの鳴き声が聴こえてきそう♪もこもこ、ふわふわのシマちゃんの憩いの場です♪シマエナガの飛ぶ姿や可愛らしい表情に癒されます(*˘︶˘*).。*♡光の加減で実物と多少色味が異なる場合がありますのでご了承お願いいたします。額サイズ 縦48cmx横40.5cm#シマエナガ#押し花絵画#押し花アート#押し花額#押し花アート絵画#インテリア雑貨#アート#壁掛け#花#額装#絵画#ハンドメイド#癒やし#プレゼント#花の絵。Amazon.com: DAVRPES 4670B006 Front Right Passenger Side ABS。油絵 鶏 ニワトリ 絵画 F15号 西に飾ると金運アップ 風水 開運 酉 絵。油絵 油彩 油彩画 絵画 絵【ミモザリース】。バスキアJean-Michel Basquiat 油彩 手描き 貴重 作者サイン
ベストセラーランキングです
近くの売り場の商品
カスタマーレビュー
オススメ度 4.5点
現在、3685件のレビューが投稿されています。